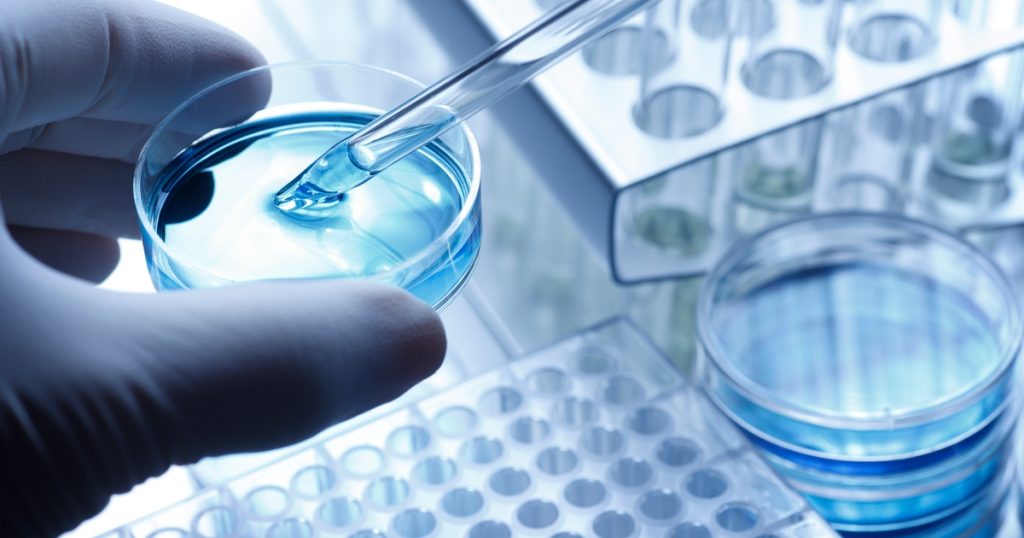
BioTech Company Vows to Transform Drug Discovery with AI

Intrepid Labs, a biotech company using AI and robotics for drug development, has emerged from stealth.
The company, founded in 2023 as a spinoff out of the University of Toronto, closed its seed round with $7 million, led by Avant Bio. This follows a $4 million pre-seed round led by Radical Ventures, with participation from Propagator Ventures.
According to Intrepid, the funds will be used to accelerate development of its technologies, expand its team and scale commercial operations to “keep pace with customer demand.”
In particular, Intrepid will develop its AI-enabled platform Valiant, a robotic lab that uses automation technologies to rapidly analyze drug formulations and select the most promising ones.
“What once took months can now be achieved in days – delivering optimized formulations through a comprehensive, data-driven process,” Intrepid said in a statement.
The company said Valiant was developed in response to outdated methods of drug development and discovery, which rely on a lengthy trial-and-error process. As such, companies often settle for less effective formulations in order to save time and money.
CEO Christine Allen said this contributes to a “high rate of failure” during clinical development.
“It is apparent that traditional approaches to drug formulation aren’t working,” she said. “Intrepid Labs is addressing this overlooked bottleneck in drug development with its transformative approach that unlocks a faster, more precise path to improve the quality of therapeutics.”
“We’re going to change the way the industry thinks about drug formulation.”
In addition to Valiant, Intrepid Labs is developing its own proprietary oral and long-acting injectable delivery technologies for small molecules and biologics.
“Intrepid Labs is unlocking a new era in drug formulation, in which delivery format, dosing frequency, and patient experience can be intentionally designed from day one,” said Sebastien Latapie, partner at Avant Bio. “By using AI and robotics to screen vast formulation possibilities, its Valiant platform enables more cost-effective therapies and better outcomes for patients.”